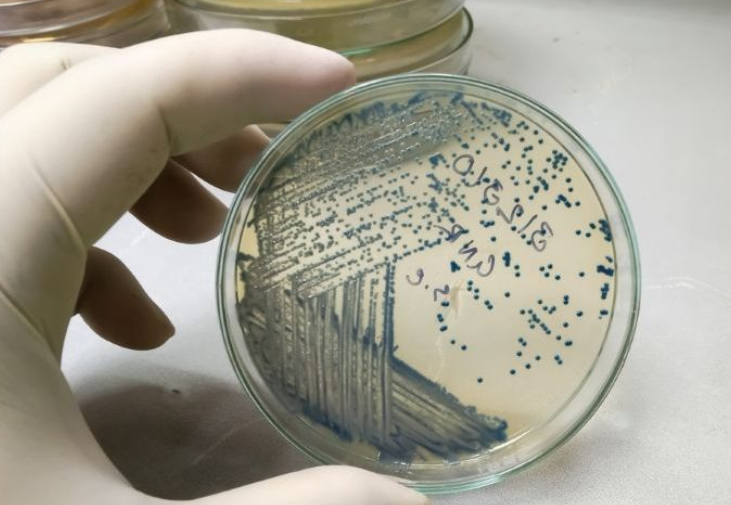

CPHI 医药中间体展会根据爱丁堡大学的一项研究了解到,原本将被填埋处理的聚对苯二甲酸乙二醇酯塑料,可被转化为帕金森病的关键药物左旋多巴。
这项创新研究表明,塑料被分解为对苯二甲酸后,经过工程改造的大肠杆菌可将这些分子转化为左旋多巴。
研究团队指出,这种新方法提供了一种可持续的途径,有助于解决基于化石燃料的PET塑料的回收难题,目前的回收工艺效率尚未达到理想水平。
工业生物技术创新与影响中心主任、副主任执行官莉兹·弗莱彻博士表示:”这个项目展示了生物学重塑我们看待废弃物方式的潜力。将塑料瓶转化为帕金森病药物不仅是一个富有创意的回收理念,更是一种重新设计流程、与自然协同工作以带来实际效益的方法。”
“通过证明有害物质可以转化为改善人类健康的东西,该团队证明了生物学的可持续、高价值应用既切实可行,又卓有成效。”
该研究团队计划进一步优化这一工艺并提升技术的可扩展性,以推动其向工业应用迈进。
CPHI 医药中间体展会获悉,在神经疾病治疗领域,此前的一项进展包括英国药品与健康产品管理局去年11月批准了卫材和渤健的抗体药物Leqembi静脉维持疗法,作为阿尔茨海默病的额外治疗选择。
最近,有研究显示可以利用废弃面包作为大肠杆菌的原料,来生成天然产生的氢气。研究结果表明,这项技术可为制药生物生产提供一种可持续的替代方案。
去年还出现了一项环境友好型创新,可能改变关键药物的生产方式。在一项研究中,研究人员成功将稻壳、玉米芯等农业废弃物转化为生产高血压治疗药物呋塞米所需的医药物质。
CPHI 医药中间体展会基于分享行业资讯的目的转载本文章,不代表我公司支持文中所述的观点,也不为全文负责真实性,如有侵权,请及时联系我们予以删除。